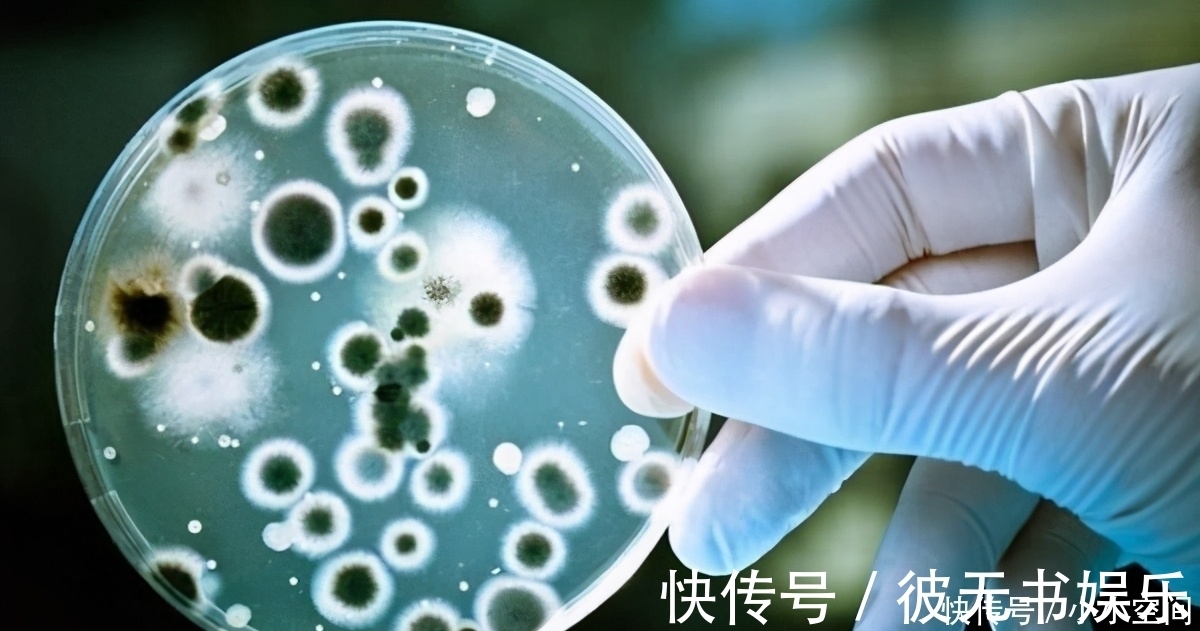
器官|65岁胃科院士，研究胃病36年，远离3件事，养胃除菌，可参考

器官|65岁胃科院士,研究胃病36年,远离3件事,养胃除菌,可参考
人体中有许多器官,它们各司其职,也相互影响,一个器官一但出现了问题,就会对其他的器官起到或多或少的影响。而胃出了问题,则会对人体的许多器官起到关键性的影响。
文章插图
胃,主人体的通降,是人体消化食物、分解养分的重要器官。人如果胃不好,那么消化能力就会变差,对食物的分解能力将会降低,人体就不能从食物中得到充足的营养补充,各大器官也就不能够得到正常补给,自然而然“工作动力”就下降了。
65岁的胃科李院士称:我国是胃病大国,许多人曾经或者现在都有过胃病,令人十分苦恼。其实这和我国的饮食习惯是分不开的,现在的生活水平提高了,在哪都能随时品尝到全国各地的美食,那吃的东西可就五花八门了,只要好吃都往嘴里放,也不管身体能不能承受得了,经常这样吃会导致胃的负担加重,胃长时间没能得到休息,不能排毒和自我修复,自然就会让胃受到损伤,降低胃的免疫力,产生胃病也不是什么稀奇的事了。

文章插图
院士提醒:日常三件事别常做,胃“看到”也害怕
1、熬夜
现在很多人都喜欢熬夜,还给自己安上了“夜猫子”的称号,但他们不知道的是,熬夜是极其伤胃的,因为胃工作了一天,到了晚上的时候人们休息了才能够进行自我修复和自我排毒,这是养胃的时间段,而人们太晚了还没休息,就会影响到胃部的自我修复和自我排毒时间,让胃的毒素排不出去,时间长了,胃病不来找你都难。
2、不吃早餐
不吃早餐现在已经成了人们的一个常态,为了上班和上课之前能多睡十分钟,人们常常喜欢以不吃早餐为代价来换取这十分钟的睡眠,这是不智的行为,因为晚上休息的时候胃酸也没有停止排放过,但是人已经一个晚上没有进食,胃酸没有食物来中和,就会灼伤胃粘膜,破坏胃部的环境,产生胃痛、反酸、胃炎等情况,所以早餐时一定要吃的。
3、常吃辛辣食物
【 器官|65岁胃科院士,研究胃病36年,远离3件事,养胃除菌,可参考】辛辣食物味道非常可口,许多人都喜欢吃,但辛辣食物也不是每个人的身体都能够承受得住的,辛辣食物的刺激性很强,极其容易破坏胃粘膜,而且容易对胃产生伤害,人们吃了辛辣食物后容易产生烧心、胃痛、肚子火辣等情况,这也是伤胃的表现。

文章插图
注意,天冷了要多穿衣服,因为胃是很怕寒的,极其容易受寒,每天早上也可以喝一杯温开水,这样有助于中和胃部的胃酸以及暖胃养胃,最后,每餐要记得准时吃饭,这样胃病就很难来找你啦。
- 健康长寿|五十岁以后,保护这几个器官,做好这几件事,长寿可能会伴随你
- 【天使小课堂】构音障碍训练方法和构音器官运动练习
- 瓣膜|人类器官移植史上 “二师兄”为何成为“天选之子”?
- 苹果|长期走路有助于长寿吗?过了65岁的老人,尽量做好这5件事?
- 众所周知|65岁大爷练就一身铜筋铁骨,医生:他的养骨经验很赞,5 个小妙招快学习
- 骨质疏松|65岁大爷练就一身铜筋铁骨,医生:他的养骨经验很赞,5 个小妙招快学习
- 植入|世界观:全球首例猪心脏移植到人体,动物器官移植靠谱吗?
- 医生|不论男女,55—65岁是养寿期,医生提醒:最好弃4习、坚持做4事
- 养肝|肝脏器官最喜欢的4物,特别是肝不好的人更应去吃,可养肝排毒
- 鸡皮|转告家人鸡身上4“器官”,也许营养少且毒素多,劝你少碰为妙
